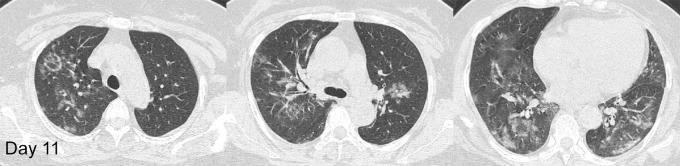
https://cdn.ncbi.nlm.nih.gov/pmc/blobs/3129/7977985/265fabb7ffa6/ryct.2020200031.fig1c.jpg

Longitudinal CT Findings in COVID-19 Pneumonia: Case Presenting Organizing Pneumonia Pattern.
作者信息
Wu Yan, Xie Yuan-Liang, Wang Xiang
机构信息
Department of Radiology, Central Hospital of Wuhan, Tongji Medical College, Huazhong University of Science and Technology, Wuhan, 430014, China.
出版信息
Radiol Cardiothorac Imaging. 2020 Feb 14;2(1):e200031. doi: 10.1148/ryct.2020200031. eCollection 2020 Feb.
Abstract
摘要